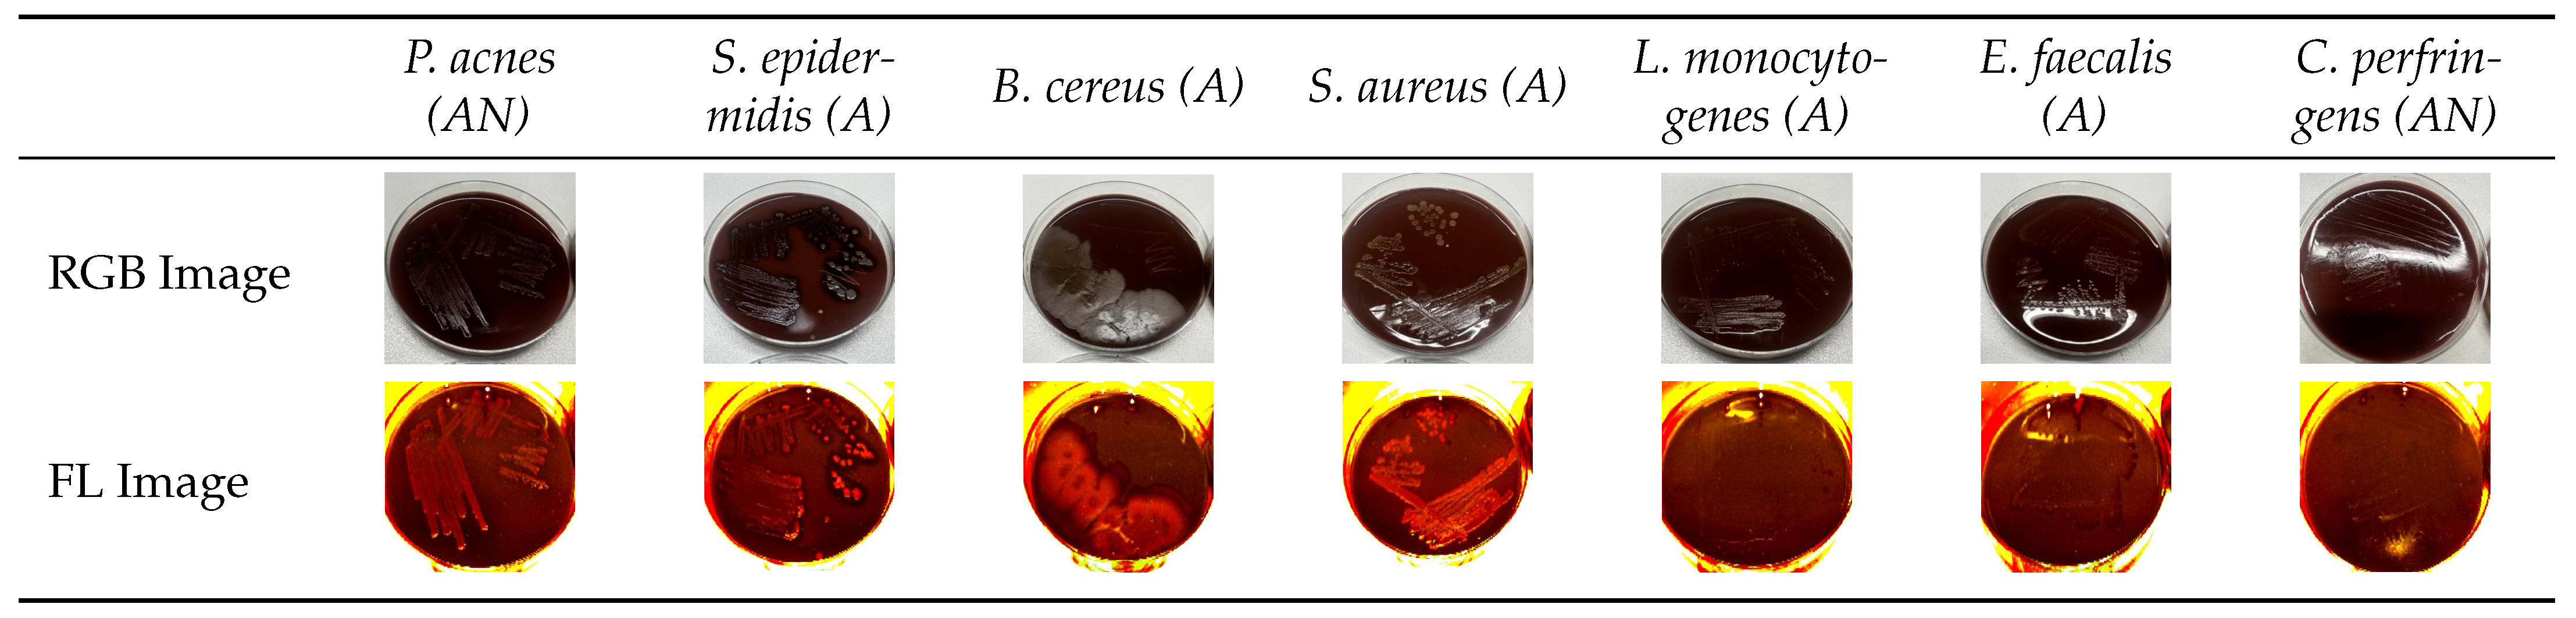
Diagnostics 15 02436 g002

Fluorescence-Based In Vitro Detection of Wound-Associated Bacteria with a Handheld Imaging System
Abstract
1. Introduction
2. Materials and Methods
2.1. Bacterial Strains
2.2. Media and Culture Conditions
2.3. Fluorescence Imaging
2.4. Image Analysis
2.5. Statistical Analysis
3. Results
3.1. Analysis of Normalized Grayscale Intensities of Various Bacterial Strains
3.2. Statistical Evaluation of Bacterial Fluorescence Signal Compared to Control
3.3. Grayscale Intensity in Relation to Gram Staining and Oxygen Requirement
4. Discussion
4.1. General Findings
4.2. Statistics
4.3. Clinical Relevance
4.4. Surgical Context
4.5. Standardization Scale
4.6. Clinical Prospects
5. Conclusions
Author Contributions
Funding
Data Availability Statement
Acknowledgments
Conflicts of Interest
Abbreviations
| ALA | δ-Aminolevulinic Acid |
| APC | Article Processing Charge |
| CFU | Colony-Forming Units |
| DSM-ID | Identifier from the German Collection of Microorganisms and Cell Cultures (DSMZ) |
| FL | Fluorescence |
| IQR | Interquartile Range |
| JPEG | Joint Photographic Experts Group (image format) |
| LED | Light-Emitting Diode |
| lx | Lux (illuminance unit) |
| NaCl | Sodium Chloride |
| nm | Nanometer |
| PCR | Polymerase Chain Reaction |
| RGB | Red-Green-Blue (color image format) |
| ROI | Region of Interest |
| SD | Standard Deviation |
| TSA | Tryptic Soy Agar |
References
- Wolcott, R.D.; Rhoads, D.D.; Dowd, S.E. Chronic wounds and the medical biofilm paradigm. J. Wound Care 2010, 19, 45–53. [Google Scholar] [CrossRef]
- Liu, Y.; Long, S.; Wang, H.; Wang, Y. Biofilm therapy for chronic wounds. Int. Wound J. 2024, 21, e14667. [Google Scholar] [CrossRef]
- Berenguer-Pérez, M.; Manzanaro-García, N.; González-de la Torre, H.; Durán-Sáenz, I.; Hernández Martínez-Esparza, E.; Diaz Herrera, M.Á.; González Suárez, B.; Verdú-Soriano, J. Systematic review and meta-analysis of diagnostic test accuracy in chronic wound’s microbiology. Int. Wound J. 2024, 21, e70063. [Google Scholar] [CrossRef]
- Frasier, K.; Li, V.; Christoforides, S.; Daly, K.; Loperfito, A.; Stech, K.; Dragovic, M. The Impact of Psychosocial Influences on Chronic Wound Healing. Open J. Med. Psychol. 2024, 13, 39–57. [Google Scholar] [CrossRef]
- Zhu, Y.; Guo, Y.; Feng, Y.; Li, Y.; Wang, Y. Health-related quality of life in patients with chronic wounds: A cross-sectional study. Int. Wound J. 2022, 19, 1634–1646. [Google Scholar] [CrossRef]
- Renner, R.; Erfurt-Berge, C. Depression and quality of life in patients with chronic wounds: Ways to improve well-being, wound healing and compliance. Chronic Wound Care Manag. Res. 2017, 4, 143–151. [Google Scholar] [CrossRef]
- Liu, C.; Ponsero, A.J.; Armstrong, D.G.; Lipsky, B.A.; Hurwitz, B.L. The dynamic wound microbiome. BMC Med. 2020, 18, 358. [Google Scholar] [CrossRef] [PubMed]
- Bowler, P. Wound microbiology and associated approaches to wound management. Clin. Microbiol. Rev. 2001, 14, 244–269. [Google Scholar] [CrossRef] [PubMed]
- Kelso, M.R.; Jaros, M. Improving Wound Healing and Infection Control in Long-term Care with Bacterial Fluorescence Imaging. Adv. Skin Wound Care 2024, 37, 471–479. [Google Scholar] [CrossRef] [PubMed]
- Battisti, A.; Morici, P.; Sgarbossa, A. Fluorescence lifetime imaging microscopy of porphyrins in Helicobacter pylori Biofilms. Pharmaceutics 2021, 13, 1674. [Google Scholar] [CrossRef]
- Carpenter, J.; Rader, M. Workflow of Healthcare Professionals Utilizing Fluorescence Imaging for Detecting Wound Bacterial Infections. Cureus 2025, 17, e85285. [Google Scholar] [CrossRef]
- Nitzan, Y.; Kauffman, M. Endogenous porphyrin production in bacteria by δ-aminolaevulinic acid and subsequent bacterial photoeradication. Lasers Med. Sci. 1999, 14, 269–277. [Google Scholar] [CrossRef]
- Li, J.; Nambu, T.; Wang, C.; Takigawa, H.; Maruyama, H.; Mashimo, C.; Okinaga, T. Optimizing Red Light-Based Photodynamic Therapy for Effective Bactericidal Action Against Fusobacterium nucleatum Subspecies. Pathogens 2024, 13, 1016. [Google Scholar] [CrossRef]
- McFarland, J. The nephelometer: An instrument for estimating the number of bacteria in suspensions used for calculating the opsonic index and for vaccines. JAMA 1907, 49, 1176–1178. [Google Scholar] [CrossRef]
- Lennon, Á.M.; Brune, L.; Techert, S.; Buchalla, W. Fluorescence spectroscopy shows porphyrins produced by cultured oral bacteria differ depending on composition of growth media. Caries Res. 2023, 57, 74–86. [Google Scholar] [CrossRef]
- Ackermann, M. A functional perspective on phenotypic heterogeneity in microorganisms. Nat. Rev. Microbiol. 2015, 13, 497–508. [Google Scholar] [CrossRef]
- Yoon, S.A.; Park, S.Y.; Cha, Y.; Gopala, L.; Lee, M.H. Strategies of Detecting Bacteria Using Fluorescence-Based Dyes. Front. Chem. 2021, 9, 743923. [Google Scholar] [CrossRef] [PubMed]
- Monici, M. Cell and tissue autofluorescence: Research and diagnostic applications. Biotechnol. Annu. Rev. 2005, 11, 227–256. [Google Scholar] [CrossRef]
- Lennon, J.T.; Jones, S.E. Microbial seed banks: The ecological and evolutionary implications of dormancy. Nat. Rev. Microbiol. 2011, 9, 119–130. [Google Scholar] [CrossRef]
- Shade, A.; Peter, H.; Allison, S.D.; Baho, D.L.; Berga, M.; Bürgmann, H.; Huber, D.H.; Langenheder, S.; Lennon, J.T.; Martiny, J.B.H.; et al. Fundamentals of microbial community resistance and resilience. Front. Microbiol. 2012, 3, 417. [Google Scholar] [CrossRef] [PubMed]
- Wilcoxon, F. Individual comparisons by ranking methods. Biom. Bull. 1945, 1, 80–83. [Google Scholar] [CrossRef]
- Demšar, J. Statistical Comparisons of Classifiers over Multiple Data Sets. J. Mach. Learn. Res. 2006, 7, 1–30. [Google Scholar]
- Mann, H.B.; Whitney, D.R. On a test of whether one of two random variables is stochastically larger than the other. Ann. Math. Statist. 1947, 18, 50–60. [Google Scholar] [CrossRef]
- Yao, X.; Jericho, M.; Pink, D.; Beveridge, T. Thickness and elasticity of gram-negative murein sacculi measured by atomic force microscopy. J. Bacteriol. 1999, 181, 6865–6875. [Google Scholar] [CrossRef] [PubMed]
- Matias, V.R.F.; Beveridge, T.J. Cryo-electron microscopy reveals native polymeric cell wall structure in Bacillus subtilis 168 and and the existence of a periplasmic space. Mol. Microbiol. 2005, 56, 240–251. [Google Scholar] [CrossRef]
- Rohde, M. The Gram-Positive Bacterial Cell Wall. Microbiol. Spectr. 2019, 7, GPP3-0044-2018. [Google Scholar] [CrossRef]
- Plavskii, V.Y.; Mikulich, A.V.; Tretyakova, A.I.; Leusenka, I.A.; Plavskaya, L.G.; Kazyuchits, O.A.; Dobysh, I.I.; Krasnenkova, T.P. Porphyrins and flavins as endogenous acceptors of optical radiation of blue spectral region determining photoinactivation of microbial cells. J. Photochem. Photobiol. B Biol. 2018, 183, 172–183. [Google Scholar] [CrossRef]
- Sun, J.; Vellappan, S.; Akdemir, J.; Steier, L.; Feinbloom, R.E.; Yadavalli, S.S. Imaging of porphyrin-specific fluorescence in pathogenic bacteria in vitro using a wearable, hands-free system. J. Microbiol. Methods 2025, 237, 107225. [Google Scholar] [CrossRef]
- Zhou, P.; Li, X.; Qi, F. Identification and characterization of a haem biosynthesis locus in Veillonella. Microbiology 2016, 162, 1839–1848. [Google Scholar] [CrossRef] [PubMed]
- Wörner, J.; Moelleken, M.; Dissemond, J.; Pein-Hackelbusch, M. Supporting wound infection diagnosis: Advancements and challenges in the use of electronic noses. Front. Sens. 2023, 4, 1250756. [Google Scholar] [CrossRef]
- Baron, E.J.; Miller, J.M.; Weinstein, M.P.; Richter, S.S.; Gilligan, P.H.; Thomson, R.B., Jr.; Bourbeau, P.; Carroll, K.C.; Kehl, S.C.; Dunne, W.M.; et al. A Guide to Utilization of the Microbiology Laboratory for Diagnosis of Infectious Diseases: 2013 Recommendations by the Infectious Diseases Society of America (IDSA) and the American Society for Microbiology (ASM). Clin. Infect. Dis. 2013, 57, e22–e121. [Google Scholar] [CrossRef] [PubMed]
- Jorgensen, J.H.; Ferraro, M.J. Antimicrobial susceptibility testing: A review of general principles and contemporary practices. Clin. Infect. Dis. 2009, 49, 1749–1755. [Google Scholar] [CrossRef]
- Tong, S.; Davis, J.; Eichenberger, E.; Holland, T.; Fowler, V.J. Staphylococcus aureus infections: Epidemiology, pathophysiology, clinical manifestations, and management. Clin. Microbiol. Rev. 2015, 28, 603–661. [Google Scholar] [CrossRef]
- Serena, T.E.; Snyder, R.J.; Bowler, P.G. Use of fluorescence imaging to optimize location of tissue sampling in hard-to-heal wounds. Front. Cell. Infect. Microbiol. 2023, 12, 1070311. [Google Scholar] [CrossRef] [PubMed]
- Automation of the Microbiological System. 2025. Available online: https://bactomatic.pl/en/automation-of-the-microbiological-system/ (accessed on 12 September 2025).
- Aerden, D.; Bosmans, I.; Vanmierlo, B.; Spinnael, J.; Keymeule, B.; Van den Brande, P. Skin grafting the contaminated wound bed: Reassessing the role of the preoperative swab. J. Wound Care 2013, 22, 85–89. [Google Scholar] [CrossRef] [PubMed]
- Høgsberg, T.; Bjarnsholt, T.; Thomsen, J.S.; Kirketerp-Møller, K. Success Rate of Split-Thickness Skin Grafting of Chronic Venous Leg Ulcers Depends on the Presence of Pseudomonas aeruginosa. PLoS ONE 2011, 6, e20492. [Google Scholar] [CrossRef]
- Lee, W.; Kim, Y.; Kim, M.; Chung, S.; Lee, J. Analysis of Skin-Graft Loss Due to Infection. Ann. Plast. Surg. 2005, 55, 102–106. [Google Scholar] [CrossRef]

| Bacterial Species | Description | DSM ID | Growth Medium |
|---|---|---|---|
| Staphylococcus aureus | Aerobic, Gram + | 799 | TSA |
| Staphylococcus epidermidis | Aerobic, Gram + | 20044 | TSA |
| Pseudomonas aeruginosa | Aerobic, Gram − | 1128 | TSA |
| Pseudomonas putida | Aerobic, Gram − | 291 | TSA |
| Enterococcus faecalis | Aerobic, Gram + | 20478 | TSA |
| Escherichia coli | Aerobic, Gram − | 1576 | TSA |
| Proteus mirabilis | Aerobic, Gram − | 6674 | TSA |
| Serratia marcescens | Aerobic, Gram − | 1636 | TSA |
| Acinetobacter baumannii | Aerobic, Gram − | 30007 | TSA |
| Klebsiella pneumoniae | Aerobic, Gram − | 789 | TSA |
| Klebsiella oxytoca | Aerobic, Gram − | 5175 | TSA |
| Propionibacterium acnes | Anaerobic, Gram + | 1897 | Columbia Blood Agar |
| Bacteroides fragilis | Anaerobic, Gram − | 9669 | Columbia Blood Agar |
| Aeromonas hydrophila | Aerobic, Gram − | 30187 | TSA |
| Alcaligenes faecalis | Aerobic, Gram − | 30030 | TSA |
| Bacillus cereus | Aerobic, Gram + | 31 | TSA |
| Citrobacter freundii | Aerobic, Gram − | 24397 | TSA |
| Clostridium perfringens | Anaerobic, Gram + | 756 | Columbia Blood Agar |
| Listeria monocytogenes | Aerobic, Gram + | 20600 | TSA |
| Veillonella parvula | Anaerobic, Gram − | 2008 | Columbia Blood Agar |
| Parameter | Specification | Remarks |
|---|---|---|
| Test procedure | Detection on solid media via light emission at 405 nm | Based on porphyrin fluorescence |
| Test strains | See Table 1 | Reference strains from DSMZ |
| Culture media | TSA, Columbia Blood Agar | Depending on species |
| Inoculum concentration | CFU/mL | In 0.85% NaCl |
| Test medium | Chocolate Agar + ALA (250 mM, 400 µL) | Stored at 4 °C for 4 days |
| Incubation temperature | 36 ± 2 °C | Standard microbiological conditions |
| Incubation time | 24–96 h (aerobes); 5–7 days (anaerobes) | Species-dependent |
| Replicates per strain | 3 plates | Triplicates for reproducibility |
Disclaimer/Publisher’s Note: The statements, opinions and data contained in all publications are solely those of the individual author(s) and contributor(s) and not of MDPI and/or the editor(s). MDPI and/or the editor(s) disclaim responsibility for any injury to people or property resulting from any ideas, methods, instructions or products referred to in the content. |
© 2025 by the authors. Licensee MDPI, Basel, Switzerland. This article is an open access article distributed under the terms and conditions of the Creative Commons Attribution (CC BY) license (https://creativecommons.org/licenses/by/4.0/).
Share and Cite
Horn, J.; Dalinskaya, A.; Paluch, E.; Nord, F.-O.; Ruopp, J. Fluorescence-Based In Vitro Detection of Wound-Associated Bacteria with a Handheld Imaging System. Diagnostics 2025, 15, 2436. https://doi.org/10.3390/diagnostics15192436
Horn J, Dalinskaya A, Paluch E, Nord F-O, Ruopp J. Fluorescence-Based In Vitro Detection of Wound-Associated Bacteria with a Handheld Imaging System. Diagnostics. 2025; 15(19):2436. https://doi.org/10.3390/diagnostics15192436
Chicago/Turabian StyleHorn, Jonas, Anna Dalinskaya, Emil Paluch, Finn-Ole Nord, and Johannes Ruopp. 2025. "Fluorescence-Based In Vitro Detection of Wound-Associated Bacteria with a Handheld Imaging System" Diagnostics 15, no. 19: 2436. https://doi.org/10.3390/diagnostics15192436
APA StyleHorn, J., Dalinskaya, A., Paluch, E., Nord, F.-O., & Ruopp, J. (2025). Fluorescence-Based In Vitro Detection of Wound-Associated Bacteria with a Handheld Imaging System. Diagnostics, 15(19), 2436. https://doi.org/10.3390/diagnostics15192436

